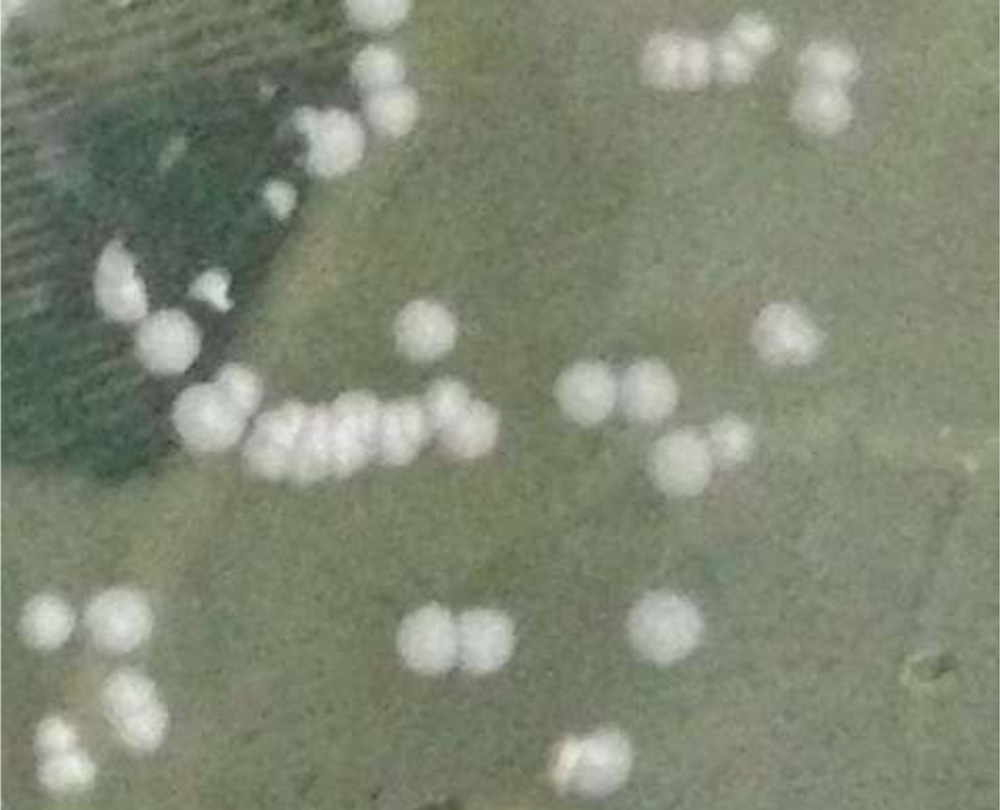

Dr. Vineet Joshi, J16868, Dr. Prabhu Shanker M.
Vineet Joshi, M Prabhushanker, Jagadeshkumar Reddy
Cataract extraction is the most commonly performed ophthalmic surgical procedure in India(1). In the year 2000 approximately 3.5 million cataract surgeries were performed in India(2). Considering these high number of surgeries being conducted, it is important to take the surgical complications into account, most importantly post-operative endophthalmitis.Endophthalmitis can be either exogenous resulting from breach of the globe exteriorly because of surgery or trauma or endogenous due to hematogenous spread.(3)Most of the exogenous postoperative endophthalmitis develop after cataract surgery annually worldwide.(3) Post-cataract endophthalmitis is a serious complication leading to poor visual outcome.(4) Especially in India, exogenous postoperative endophthalmitis after cataract surgery is more common than endogenous endophthalmitis.(5) According to a study on Asian population the incidence rate of post-operative Endophthalmitis was about 0.07%(6).
Most common pathogenic organisms are Gram positive coagulase negative Staphylococcus followed by Streptococcus species, Staphylococcus aureus and Gram negative organisms (Enterococci).(7)(8) In India, Gram negative organisms particularly Pseudomonas aeruginosa and fungi (Fusarium and Aspergillus species) are also seen frequently in exogenous endophthalmitis.(9)(10) But certain rare organisms are found to be causative agents in post-operative endophthalmitis which are chronic, indolent and have poor visual prognosis, like Nocardia and atypical mycobacteria.(11–13). Nocardia species is of increasing concern in today’s cataract surgery scenario. Most commonly in the western countries, Nocardiaendophthalmitis has been observed as a sporadic entity due to either endogenous spread in immunocompromised patients or exogenously after trauma.(14,15)
On the contrary, in South Asia, Lalitha et al reported a ;ostoperative endophthalmitis rate of 0.05%.(16)andNocardia species was the commonest organism isolated from culture positive cases (60% ). Also an earlier study from Sridhar et al reported that Nocardia constituted 1.7% of all culture positive samples from bacterial cultures of keratitis patients.(17) While recently, in a review of culture-positive samples from bacterial keratitis, it was found that Nocardia was isolated from 8.34% of cases (95 cases out of 1139 in the years 2006–2008; unpublished data).(18) This points towards an alarming increase in the incidence of Nocardia culture positive cases in this part of the country.
Nocardia is a filamentous, thin branching, Gram positive acid fast organism which is a soil saprophyte. It is characterized by a typical slow growth on culture plates. Nocardia is a organism commonly present in the soil of South India.(19) It presents as keratitis, scleritis or endophthalmitis.(20)Nocardiaasteroides was the most common species isolated in culture positive case reports, but recently in cultures of anterior chamber, corneo-scleral scrapings, newer species like N.arthrides, N. neocaledoniensis, N. asiatica, have been isolated.(21)(12,22)
Routinely in addition to culture, identification of a clinical bacterial isolate requires one to perform a battery of phenotypic and genetic (DNA-DNA hybridisation& 16sRNA) tests which require a long time, long incubation period, multiple number of biochemical tests and a considerable expertise. A newer rapid and reliable diagnostic method to diagnose species is matrix-assisted laser desorption-ionization-time–of-flight mass spectrometry (MALDI-TOF). This is a type of proteomic analysis, wherein a typical protein based finger-print of each organism is generated and is compared with the pre-loaded spectrum of source data, thus giving an accurate identification. (23) MALDI-TOF has been successfully used before to identify individual species of Nocardia.(24)
The initial clinical picture resembles to fungal endophthalmitis and often empirical antifungal treatment is started until confirmation of diagnosis.(25) But based on previous studies few clinical features like yellowish white anterior chamber exudates, iris and corneal endothelial nodules, scleral thinning and abscess, hypopyon with membrane over intra-ocular lens (IOL) have been noticed in Nocardiaendophthalmitis.(26)Anterior chamber wash, intravitreal antibiotics alongwith pars planavitrectomy (PPV) and intra-ocular lens explantation have been done based on the severity.(11,27) Presentation of endophthalmitis is less common than keratitis.(20) It was found that in a study that the incidence of Nocardia culture positive endophthalmitis was 0.064% but the visual outcome of Nocardiaendophthalmitis is poor compared with that of only corneal or scleral involvement.(20)
Currently amikacin, is one of the main line of treatment. Other drugs like ofloxacin, ciprofloxacin, gentamycin and oral co-trimoxazole combination are also effective. Previously sulfacetamideeyedrops along with trimethoprim-sulfamethoxazole combination was given as initial therapy.(28) But due to growing multi-drug resistance to newer cefalosporins, trimethoprim-sulfamethoxazole, nowadays amikacin and imipenem have become the newer treatment of choice for nocardiosis.(29)Imipenem and amikacin administered systemically can treat systemic nocardiosis. Intra-vitrealimipenem has been tried experimentally and has good results in controlling pseudomonas infection.(30) It has found to be non-toxic to retina in low doses.(31)It is a good alternative to amikacin. Amikacin can be given intra-vitreally, intra-venously and also topically. Recently few study reports have shown successful treatment of Nocardiaendophthalmitis with linezolid.(32) In fact few study reports of endogenous Nocardial infections have shown better results after systemic linezolid and minocycline therapy.(33)Intra-vitrealvancomycinandfortified vancomycin eye drops are frequently added to the treatment as it shows good sensitivity to Nocardiaand also covers other Gram positive spectrum of infections and are given empirically.(26) Due to delayed culture positivity of Nocardia, many a times an empirical antibacterial therapy has been started for endophthalmitis which included vancomycin, ceftazidime and antifungal therapy including amphotericin B, due to overlap of presenting clinical picture.(22,25) But Nocardia is known to develop microbial resistance sooner than other organisms as a result of which many species have been found with either reduced sensitivity or resistance to vancomycin as well as ceftazidime.(34–37)Amikacin being the treatment of choice for ocular Nocardiosis, it is essential to start amikacin as a first line treatment, and thus this delay in initiating appropriate treatment could lead to poor visual outcome.(26,36)
Nocardialendophthalmitis is a rare ocular infection and has a high morbidity with poor visual prognosis.One reason may be the delay in diagnosis because of a lack of familiarity. Another reason could be the lack of consensus on an appropriate treatment modality. Yet inspite of effective treatment it is evident that the severity of presentation and progression of the disease has profound effect on the final prognosis. With the advent of amikacin and vancomycin resistant species of Nocardia, it has become even more important to study the risk factors and identify the possible preventive measures and find newer treatment options against Nocardialendophthalmitis after cataract surgery.
A certain species N.transvalensis has also recently been found to be resistant to amikacin.(38)Specific species might have characteristic virulence inside the eye based on its pathogenic mechanisms, like Nocardiafarcinica showing characteristic resistance to most of the newer cephalosporins.(35) Identifying species can also aid further in subsequent studies to understand the genes expressed more often, or to identify newer biomarkers to diagnose the infection earlier. Also it can help in identifying specific clinical features pertaining to any specific species.Identifying the species of the culture isolates can help trace the source of the infection. Source of the infection could be soil in nails, hands, hair of patients or transmitted intra-operatively, through open air conductions in operation theatre, operation theatre gowns.(39) Preventive measures in these directions can play a big role in improving the visual outcome.
Therefore, more studies are essential to study the species and factors affecting visual prognosis in Nocardiaendophthalmitis cases. We wish to analyze consecutive culture proven cases of Nocardial infections after cataract surgery so as to examine their clinical presentation, microbiological profile, different modes of management, and anatomical and functional outcome. Prompt recognition of the clinical features of Nocardialendophthalmitis after cataract surgery and a better understanding of the response to current management options may potentially improve the prognosis of this disease. It is important to analyze the microbiological cultural isolates and correlate their clinical presentations to study this pattern of disease. Also besides amikacin better knowledge of other drug sensitivities will help in formulating newer treatment strategies.
Purpose of the study was
- To correlate clinical features of Nocardiaendophthalmitis with the functional and anatomical visual outcome.
- To correlate microbiological parameters like antibiotic drug sensitivity, type of Nocardia species, with the clinical features and visual outcome in patients post- cataract surgery.
This was a Prospective study of consecutive cases of Nocardiaendophthalmitis was conducted in an academic setting from October 2011 to October 2015. Endophthalmitis patients post-cataract surgery with culture positive for Nocardia organism.
All patients were evaluated at a tertiary eye hospital. The study was performed with institutional ethics and scientific committee approval board approval. Only culture-positive cases of Nocardia were included in this study. All the patients underwent either
1) Temporal section manual SICS (small incision cataract surgery) in which a 6-6.5mm scleral incision was given and nucleus was extracted through a corneo-scleral tunnel after a capsulorrhexis and complete hydrodissection or
2) Phacoemulsification through a 6 mm temporal scleral tunnel. No clear corneal incisions were made.
PMMA (polymethyl-methacrylate) intra-ocular lens (IOL) was implanted in all the patients.
History and Examination
Following details of patient were recorded based on patients detailed History.
- Age, Sex, Locality, Occupation, Co-morbid systemic illness, Type of cataract surgery, Complications during cataract surgery, Time gap between cataract surgery and onset of symptoms (latent period), Co-existent eye disorders, Visual acuity at presentation and History of Trauma
Examination
All the patients were operated for cataract surgeries. Patients presenting with pain, diminution of vision after surgery were examined thoroughly to look for signs suggestive of Nocardia etiology.
- Slit Lamp Bio-microscopic examination
Detailed Examination of the eye recording clinical features of Cornea, Sclera and Anterior Chamber, Lens and Posterior chamber was done with the help of TOPCON SL-7 1116740
- Posterior segment examination –
- B-scan Ultrasonography
B-scan ultrasonography of the affected eye was done to look for posterior segment involvement with the help of Ophthalmic Technologies Inc, Toronto, Canada M3J3E5.
If the media was clear other methods of posterior segment evaluation were attempted like Indirect Ophthalmoscopy and Optical Coherence Tomography.
Media-Clarity Scoring- grade 5 (absent red reflex), grade 4 (vessels not seen, red reflex present), grade 3 (some retinal vessels seen), grade 2 (media clear but worse than 20/40, second-order retinal vessels seen), grade 1(better or equal to 20/40 view to retina).(43)
Clarity of media was recorded by Heine Sigma 150 KC Indirect Ophthalmoscope.
Clinical Features Suggestive of Nocardia Infection
Salient features of Nocardial infection after cataract surgery as per few previous studies were looked for with a primary clinical suspicion. (20,26,41)
1) Corneal endothelial exudates (Fluffy exudates) (26)
Fig:2- Corneal Endothelial Exudate with Hypopyon and Fig:3- Fluffy corneal endothelial exudate.
2) Anterior chamber Exudates/ Iris (Cottonball exudates)(18,26)

Fig:4- Dense AC Exudates

Fig:5- Cottonball exudate in AC with Hypopyon.
3) Surgical Sectional infiltrates (26)

Fig:6- Surgical Sectional Infiltrate at the temporal scleral tunnel.
4) Scleral Abscess(26)

Fig:7:- Scleral Abscess in NocardialEndophthalmitis
5) Hypopyon- as seen in Figure 2 and Figure 5.
6) Posterior segment involvement in the form of vitritis, vitreous opacities, partial or complete retinal detachment, sub-retinal fluid

Fig: 8-B-scans of 2 patients included in the study 1) showing dense vitreous opacities 2) showing vitiritis with Retinal detachment
7) Hyphema
Presence of these salient clinical features raise the suspicion of NocardialEndophthalmitis and the patients were considered to begin with empirical treatment for Nocardia.
4.10.Microbiological Examination
Isolation of Nocardia.
The specimens to be used for microbiology workup were collected under aseptic precautions
- Corneal scrapings/tissue biopsy
Corneal tissue obtained while performing Therapeutic keratoplasty or corneo-scleral patch graft was taken, cut into small pieces and inoculated on blood agar and Saboraud’s dextrose agar (SDA). To collect scrapings under aseptic conditions, 1-2drops of local anesthetic 2% lignocaine were instilled into the eye and with a 15 number sterile blade corneal scrapings along the limbus, surgical section, and scleral margins around the abscess (in cases of scleral abscess) were taken. If any frank exudates, they were taken and transferred onto a blood agar a SDA in a C pattern.
2) Scleral scrapings/in cases of scleral abscess and sectional infiltrates were taken similarly like corneal scrapings.
3) Conjunctival swab
Conjunctival swab was taken with a charcoal swab, by swabbing superior inferior medial and lateral fornices and also the lid margins. Swab was inoculated directly on blood agar and SDA.
4) Anterior chamber aspirates in cases of dense anterior chamber exudates
Under aseptic conditions, 26G needle with tuberculin syringe was inserted at the level of limbus and anterior chamber contents (exudates or pus or aqueous humor ) were aspirated. Corneal Endothelial exudates, AC Exudates are thicker and can lead to a dry tap. At such times a peripheral entry is made with a side-port away from the surgical section and thicker exudates are isolated with a non-toothed forcep under aseptic conditions. These were then inoculated directly onto the blood agar and SDA.
5) Vitreous tap was performed by a 26G needle through pars plana route 3.5mm from limbus with a tuberculin syringe. In case of a dry tap vitrous biopsy was performed with a vitrectomy cutter from pars plana route.
Additionaly nail clippings from fingers were taken in Nocardia culture positive cases to try and identify the source of organism.
Part of the specimens were inoculated in the culture media such as in Blood agar, Sabourauds Dextrose agar and they were incubated at 37’C in the incubator. In first 48 hours the plates were examined for colonies. If sufficient colonies were not seen, the plates were continued to be incubated for 1 week and examined daily before labelling as culture sterile.(18,44) The growth yielded cultures were identified and confirmed for presence of Nocardia by
- Microscopy – Staining characteristics and morphology of Nocardia
- Culture – Characteristic morphology of colonies cultured.
- MALDI-TOF Proteomic analysis for species-
- Microscopy
Each sample was smeared on clean pre-sterilized glass slides for microscopic examination using Gram stain, and potassium hydroxide (KOH) 10%. 1% or 20% acid-fast Ziehl-Neelsen (ZN) stain was used when Gram positive filamentous filamentous organisms were seen with a strong clinical suspicion of Nocardia.
A positive smear for Nocardia was defined as gram-positive thin branching filaments on Gram stain or thin branching filaments on KOH preparation, or ZN acid-fast staining.(26)

Fig:11- Filamentous bacteria staining positive with 1% ZeilNeilsen(ZN) acid fast staining suggestive of Nocardia
- Culture
The specimens were also inoculated onto sheep blood agar, chocolate agar, Sabouraud dextrose agar.(18,44) The culture was considered significant when there was; 1) growth of the same organism on 2 or more media; 2) confluent growth at the site of inoculation on 1 solid media; or 3) growth in 1 medium with consistent direct microscopy findings.(26) The typical appearance of Nocardia colonies is dense chalky white colonies with presence of reductus on surface or molar tooth like appearance.(45). Certain colonies of nocardia can be identified by characteristic pigment production.
Fig:14- Central dense and peripheral pale colour gives enamel tooth-like or reductus appearance

Fig:17-Nocardia colonies producing pigments
3) MALDI-TOF Proteomic analysis for species- The isolated genus of Nocardia organisms are further identified up to species by Matrix assisted laser desorption/ionization (MALDI)-TOF (time-of-flight mass spectrometer). The samples were analyzed using a microflex LT MALDI-TOF MS instrument (BrukerDaltonik GmbH, Bremen, Germany).

Fig:18- MALDI-TOF Biotyper machine by BRUKER technology
Rapid and accurate methods of identifying species of bacteria depend on phenotypic and genetic methods. Phenotypic methods include staining, culture and serology while genetic methods include (DNA & RNA analysis) which are time consuming, expensive and also need certain expertise. MALDI-TOF requires a simple and straight-forward sample preparation by culture and a very short period of time to produce the results.(23)
MALDI methodology is based on proteomic principle. It identifies proteins in mass range between 2 and 20 kDa (kilo Dalton) by calculating their mass (m) to charge (z), m/z values.
Spectra were recorded in the positive linear mode with an accelerating voltage of 20 kV and analyzed over a mass range of 2,000 to 20,000 Da. Each series of measurements was preceded by calibration with a bacterial test standard (BTS 255343; BrukerDaltonik).(24). Based on the proteins pertaining to a peculiar species a proteomic finger print spectrum is generated which is downloaded into the machine database by MALDI BioTyper software. Then the original MALDI BioTyper database version 3.0.2 bearing the spectra of 3,486 cellular organisms compares the different spectra and identifies the species.

Fig:19- Report of one isolate by MALDI-TOF analysis
Using MALDI-TOF proteins specific to a particular Nocardia species can be identified based on the purity of the culture media. Ideally the cultures should be freshly revived and then sent for MALDI analysis within 48 hours. For a particular species the MALDI-TOF spectrometer will provide a correction factor, which has to be more than 0.7, which indicates specificity of that species. The correction factor depends on the purity of the culture. Accuracy of MALDI TOF as reported by a few studies 87.8% in bacterial isolates and 88% for nocardial isolates(23)(24).
- Antimicrobial susceptibility Test
Antimicrobial susceptibility testing was done by the Kirby Bauer disk diffusion method.(26)Amikacin, vancomycin, moxifloxacin, gatifloxacin, ofloxacin, tobramycin, linezolid, chloramphenicol, co-trimoxazole, ceftazidime, amoxicillin-clavulanic acid, ampicillin, erythromycin and doxycycline were studied. The sensitivity pattern was analyzed based upon the disc diffusion method guidelines for drug susceptibility of Nocardia.(46)
4.11.Treatment
Initial treatment was started based on presenting clinical features and modified according to the smear results, clinical response, culture, and antibiotic susceptibility testing. Empirically fortified Amikacin 5% eye drops hourly, fortified 5% Vancomycin drops hourly, topical gatifloxacin 0.3% 6 times a day, amikacin 125mg 8 hourly intra-venous, oral Co-trimoxazole DS , Homatropine eye drops or Atropine ointment 3 times daily along-with oral NSAIDS(non-steroidal anti-inflammatory agents ) to alleviate pain.(26)
All the patients were given intra-vitreal antibiotics (IOAB) as empirical treatment.
Vancomycin 1mg in 0.1ml
Amikacin 400 micrograms in 0.1ml
Later on patient was monitored for improvement. If there was no improvement or worsening of signs and vision, based upon the specific clinical features and microbiology reports an appropriate treatment was given.
- Repeat (IOAB) – Re-injection of intra-vitreal antibiotics, or intracameral antibiotics was given if exudates did not subside on empirical therapy.
Amikacin 400 micrograms in 0.1ml.
- Pars planavitrectomy (PPV) – if there is extensive posterior segment involvement not improving or worsening with empirical therapy (RD, Subretinal exudates, dense vitreous exudates) PPV with 23G cutter was done with or without intra-ocular lens (IOL) explantation.
- Re-surgery 1 – Anterior Segment Wash and debridement to remove all exudates alongwithintracameral antibiotics and /or intra-vitreal antibiotics IOAB and suturing of surgical section.
- Re-surgery 2 – Therapeutic Keratoplasty(TKP) or Sclero-corneal patch graft with or without IOL explantation was done in cases with non resolving infection in anterior chamber and sclero-corneal thinning at the section leading to leaking and collapse of anterior chamber. It was also done in sclero-corneal abscess, not responding to empirical treatment.
4.12.Anatomical and Functional outcome
The patients were followed to check for functional and anatomical visual status at 15 days,1 month and 3 months. The outcome at the end of 3 months was evaluated in terms of anatomic and functional success.
Anatomic success was defined as preservation of the globe, attached retina, best-corrected visual acuity of light perception or better, and no signs of active inflammation at the last follow-up examination.(26) Status of retina and signs of active inflammation were examined with B-scan Ultra-sonography and Slit lamp examination respectively.
Functional success was defined as attached retina with a best-corrected visual acuity(BCVA) of 3/60 or better at 3 months.(26)LogMAR chart was used to assess visual acuity.
4.13.Statistical Method
Statistical analysis was carried out to determine possible correlation between anatomical and functional visual outcome and the following variables:
- Patient age
- Gender
- Interval from surgery to symptoms
- Time of presentation to the hospital after the onset of symptoms
- Delay by the patient to seek help
- Visual acuity at presentation
- Corneal endothelial exudates
- Presence of AC exudate/iris nodules.
- Presence of Surgical sectional infiltrate
- Membrane over IOL
- Hypopyon
- Posterior Segment Involvement
- Scleral Abscess
- Hyphema
- Treatment Modality
- Nocardia Species
RESULTS
21 culture positive cases of Nocardia were identified in patients diagnosed with endophthalmitis after cataract surgery in 112567 patients operated at tertiary eye care centre. Out of 55 reported cases of endophthalmitis, nocardia was isolated positively from 21 cases (38.1%). Incidence of rate of NocardiaEndophthalmitis at our institute was 0.018%. There was no incidence of cluster infections.
There were 12 males and 9 females in total of 21 patients. Mean age of the patients was 64.62 +/- 8.78 years.More than half of cases (57.1%) were operated for having a mature cataract or a hard brown cataract.There was no correlation between type of cataract being operated and the anatomical and functional visual outcome (P=0.375 Chi square Fishers exact test).19 out of 21 patients (90.5%) underwent temporal section SICS(small incision cataract surgery. 1 patient underwent phacoemulsification and 1 patient had to undergo a complete lens extraction along-with the capsular bag. Except one patient, all the patients were implanted with a polymethyl-methacrylate (PMMA)IOL. 2 cases needed sutures to appose the surgical section while 1 patient had zonular dialysis.Majority of the patients 81% had immediate post-op BCVA </= +0.5 logMAR. The mean post-op BCVA (logMAR) was 0.51+/-0.37. 1 patient had post-operative BCVA of +2 logMAR. The patient was left aphakic due to a large 270 degrees zonular dialysis.
ANATOMICAL AND FUNCTIONAL VISUAL OUTCOME
Graph 14: Anatomical Visual outcome and Functional Visual outcome

At the end of 3 months 18 out of 21 patients (85.7%) had a poor functional visual outcome with BCVA less than 3/60.(Table 18 and Graph 14). 3 cases (14.3%) had successful functional visual outcome with final BCVA at 3 months being 5/60, 6/60 and 3/60 respectively. None of the cases could achieve BCVA better than 6/60.
Anatomical outcome was defined as preservation of globe, attached retina , vision better than perception of light PL+, and no signs of inflammation at 3 months. Anterior chamber chamber signs of inflammation were assessed by looking for exudates in AC, cornea, surgical section, hypopyon or hyphema on the other hand posterior segment signs were assessed by B-scan ultrasonography.
5 out of 21 cases (23.8%) had successful anatomical outcome, while 16 cases (76.2%) had an failed anatomical visual outcome at 3 months.
13 out of 21 cases had AC exudates at 3 months. 6 cases led to pthisisbulbi out of which 4 still had AC exudates at 3 months. Retinal detachment with vitritis was seen in 2 patients who also had AC exudates. 2 cases had hyphema while 1 case had total corneal melt and diffuse infiltrates in anterior chamber with scleral thinning, and had to undergo evisceration. Globe was saved in all remaining 20 cases (95.2%) out of 21. (Table 19 and Graph 15)

Graph 15: Causes of Anatomical failure at 3 monthsTable 19: Causes of anatomical failure at 3 months. RD= Retinal Detachment
INTERVAL OF SURGEY TO PRESENTATION OF SYMPTOMS, DAY OF PRESENTATION, DELAY BY THE PATIENT
The initial symptoms of pain, redness, diminution of vision, presented after a certain gap of time after surgery. The mean interval from surgery to onset of symptoms was 15.24 +/- 14.14 days ranging from 2 to 66 days.Most of the cases (81%) had onset of symptoms within 20 days of surgery (3 weeks). 6 patients had onset of symptoms within first 5 days after surgery. 4 patients had onset of symptoms after 20 days of surgery, one of which had onset on 66th day after surgery.
But it was often seen that the patients presented to the hospital with a delay. The mean day of presentation to the hospital after surgery was 26.81+/- 18.44 days. Most of the patients 66.7% presented to the hospital after 20 days (3 weeks).
The average delay by the patient to seek help was 11.57+/-11.29 days
Interval between surgery and presentation of symptoms was not associated significantly with the anatomical and functional visual outcome.
But the day of presentation of the patient after cataract surgery was associated with a suggestive significance to both the anatomical and functional visual outcome. P=0.084 and P=0.088 (suggestive significance 0.05<P<0.1). Delay by the patient to seek medical help was associated with a suggestive significance to the functional visual outcome. P=0.090(suggestive significance 0.05<P<0.1).
VISION AT PRESENTATION
2 patients (9.5%) had presenting vision of <+2 logMAR (CFCF , 6/6000), out of which one had +1.18 logMAR (4/60 Snellen equivalent) and the other had +1.47 logMAR.(2/60). 4 patients (19.1%) had +2 logMAR (CFCF at 2 feet) vision. 3 of these patients had a good functional outcome.Remaining 15 (71.4%)had presenting vision worse than or equal to hand motions (+3 logMAR). 10 of these patients had light perception and 5 had vision of hand motions. No patient presented with loss of perception of light.
In comparison of visual acuity to the anatomical and functional visual outcome we found that the vision at presentation (P=0.008**) and (P=0.004**), was statistically strongly significant (P<0.01). Similarly vision at 15 days, and 1 month were statistically significant to the final anatomical and functional visual outcome.


CLINICAL FEATURES
Table 10: Clinical findings of Nocardiaendophthalmitis
| Clinical features | No. of patients
(n=21) |
% |
| Corneal Endothelial Exudates | 14 | 66.7 |
| Iris Nodules/AC exudates | 16 | 76.2 |
| Hypopyon | 12 | 57.1 |
| Sectional /Sutural Infiltrates | 16 | 76.2 |
| Scleral Abscess | 7 | 33.3 |
| Membrane over IOL | 7 | 33.3 |
| Posterior segment involvement | 13 | 61.9 |
| Hyphema/ blood clot | 4 | 19.0 |
Most common clinical findings on presentation were presence of Anterior Chamber exudates/iris nodules/cottonball exudates (AC Exudates) in 16 patients (76.2%) and surgical wound infection in the form of Sectional/ sutural infiltrates in 16 patients (76.2%).(Table 10 and Graph7) Next common clinical finding was corneal endothelial fluffy exudates in 14 patients (66.7%). Hypopyon was also seen in anterior chamber along-with other signs in 57% patients. A scleral abscess formation in proximity to the surgical section was characteristic and seen in 7 cases (33.3%). In a few cases (4 out of 21 (19%) in late stages hyphema was seen in anterior chamber.
Posterior segment findings were seen on B-scan ultrasonography. The media clarity was assessed to decide if PPV was possible. The clarity of the ocular media at presentation was grade 5 (absent red reflex) in 14 patients, grade 4 (vessels not seen, red reflex present) in 4 patients, grade 3 (some retinal vessels seen) in 2 patients, and grade 2 (media clear, second-order retinal vessels seen) in 1 patient.
Posterior segment findings in the form of vitritis were seen in 13 cases (61.9%), dense vitreous exudates were seen in 3 patients (14.2%) and retinal thickening with retinal detachment was seen in 2 patients (9.5%). (Table 10 and Graph 7)
An infective Membrane over IOL involving the capsular bag was seen in 7 cases (33.3%). Posterior segment findings were found in lesser patients compared to the anterior segment findings. The involvement of the surgical wound was very characteristic. Side-ports made in the phacoemulsification wound also showed involvement.
Overall there was no significant association between individual clinical features and the anatomical visual outcome (P>0.1) and between clinical features and functional visual outcome (P>0.1).but in case of functional visual outcome, sectional infiltrates had the least P value=0.128. Similarly scleral abscess in association with anatomical failure had least P value= 0.123.
TREATMENT MODALITIES
Table 15: Treatment modalities
| No. of patients
(n=21) |
% | |
| Need of repeat IOAB | 10 | 47.6 |
| PPV | 3 | 14.3 |
| Anterior segment wash + IOAB (Resurgery 1) | 8 | 38.1 |
| Corneo-scleral patch graft/TKP + IOL explantation. (Resurgery 2) | 12 | 57.1 |
All the 21 patients received intra-vitrealvancomycin, ceftazidime and amikacin as an initial empirical treatment. Repeat intra-ocular antibiotics (IOAB) either intra-vitreal or intra-cameral amikacin was needed in 10 / 21 cases (47.6%), out of which 8 cases did not respond alone to this treatment and needed re-surgical interventions.
PPV had to be done in 3 cases (14.3%). All 3 cases had dense vitreous exudates while 2 of them had retinal detachment. Re-surgical intervention in the form of anterior segment debridement and wash with irrigating fluids along-with intra-cameral or intra-vitrealamikacin was done in 8 cases (38.1%). 2 out of these did not improve clinically and needed an IOL explantation with keratoplasty.
12 out of 21 cases (57.1%) were refractory to the initial treatment had to eventually undergo a corneo-scleral patch graft or a therapeutic keratoplasty due to progressive melt and sclero-corneal thinning at the surgical section. Thorough surgical debridement and removal of exudates along-with intra-cameral/intravitreal antibiotics was done. Only 1 out of 12 cases undergone keratoplasty had a good anatomical and functional visual outcome at 3 months.1 case had to undergo evisceration due to total corneal melt. IOL had to be explanted in 12 cases due to involvement of capsular bag and posterior chamber with exudates.
All the 3 patients undergoing PPV had anatomical and functional visual failure. Even in the 12 patients who underwent TKP/corneo-scleral patch graft, 9 led to anatomical failure and 11 led to functional visual failure. Although TKP/patch grafts helped secure anatomical success in 3 cases, 2 out of these did not have a good functional vision. Only 1 patient who underwent TKP/patch grafts had a functioning vision of 3/60 (+1.30 logMAR), who was on observation for aphakia and developed symptoms on 2nd day post-op and treatment was initiated immediately. The other two patients with successful functional vision reported to the hospital within 2 days of onset of symptoms and one was treated with topical & 2 intravitrealamikacin injections while the other one needed anterior segment wash with IOAB.
METHOD OF ISOLATING NOCARDIA
Table 11: Clinical samples used for isolation.
After suspecting clinically for Nocardiaendophthalmitis, clinical samples were isolated for microbial analysis. Anterior chamber exudates and corneal tissue biopsy or scrapings yielded maximum results on microscopy as well as culture, successfully isolating the organisms. 20 out of 21 (95%) anterior chamber tap procedures which included exudates in most of the cases and 9 out of 9 (100%) corneal tissue biopsy or scrapings did yield culture positivity. On the other hand only 3/12 vitreous taps (25%) and 1/3(33%) vitreous biopsies successfully isolated nocardia on microscopy and on culture. (Table 11 and Graph 8) Scleral scrapings collected in scleral abscess showed 43%positivity.
Nail clipping samples were taken to identify the source of Nocardia. They were cultured in blood agar and Saboraud’s Dextrose agar for isolation of Nocardia, but were contaminated with commensal fungi and other bacteria on all occasions. Hence the nail cultures had to be excluded from the study.
NOCARDIA SPECIES ON MALDI-TOF
Table 12: Species distribution of patients studied
| Species | No. of patients | % |
| Nocardia genus (unidentified species) | 9 | 42.9 |
| NocardiaFarcinica | 6 | 28.6 |
| NocardiaAsteroides | 3 | 14.3 |
| Nocardiacyriacigeorgica | 3 | 14.3 |
| Total | 21 | 100.0 |
After the diagnosis of Nocardia was confirmed on microscopy and culture, this study also included to identify individual species of the organism. Out of 21 culture isolates, MALDI-TOF procedure successfully identified individual species in 12 cases (57.1%). Out of which 6 isolates (28.6%) were identified as Nocardiafarcinica which is relatively a rare organism to lead to exogenous endophthalmitis. 3 (14.3%) isolates belonged to species Nocardiacyriacigeorgica and remaining 3 (14.3%) belonged to Nocardiaasteroides. Remaining 9 isolates were identified as belonging to the genus Nocardia but could not be processed further to generate accurate proteomic spectra due to impurities in the sample. Thus these were considered in a separate group as unidentified Nocardia genus group.
Majority of isolates 19 (90.5%) showed culture positivity after the 2nd day. Maximum positivity was seen between 3-4th day (66.6%). Nocardiafarcinica showed delayed culture positivity upto 4th and 5th day predominantly while remaining species showed culture positivity between 2-5th day.
Table 13: Culture positivity on which day
| Culture positivity on which day | No. of patients | % |
| 2nd day | 2 | 9.5 |
| 3rd Day | 7 | 33.3 |
| 4th day | 7 | 33.3 |
| 5th Day | 5 | 23.8 |
| Total | 21 | 100.0 |
Overall presence of Nocardia was associated with poor anatomical visual outcome (P=0.022* P<0.05) (Table 26) and with poor functional visual outcome (P=0.015* P<0.05). All 9 cases (100%) in the Nocardia genus group wherein individual species could not be identified had a failed anatomical as well as functional visual outcome at 3 months. Similarly all 6 cases in Nocardiafarcinica group had failed Functinoal visual outcome at 3 months, while 2 cases (66.7%) in Nocardiaasteroides group and 1 case (33.3%) in N.cyriacigeorgica group had successful functional visual outcome. In our study there was significant association between N.asteroides and successful functional visual outcome.(p=0.041 Fisher Exact test).
On the other hand 5 cases 1 of (N.farcinica), 2(N.asteroides) and 2(N.cyriacigeorgica) had successful anatomical outcome at 3 months. But the Nocardia genus group showed greater failure rates than N.asteroides and N.cyriacigeorgica.
We also tried to find any association between clinical findings at presentation and individual Nocardia species but there was no significant association between these two (P > 0.1)
In comparison of treatment modalities with individual species we found that there was no likelihood of a particular treatment modality being commonly needed in an individual species (P>0.1) (Table 29). Yet one important finding was that more than 50% individuals in the unidentified Nocardia group (55.6%), Nocardiafarcinica (66.7%) group and N.asteroides
group (66.7%) had to undergo surgical treatment in the form of TKP/corneo-scleral patch graft.
| Species | P value | ||||
| Nocardia genus (unidentified species)
(n=9) |
NocardiaAsteroides
(n=3) |
Nocardiacyriacigeorgica
(n=3) |
NocardiaFarcinica
(n=6) |
||
| Need of repeat IOAB/ | 5(55.6%) | 1(33.3%) | 1(33.3%) | 3(50%) | 1.000 |
| PPV | 1(11.1%) | 0(0%) | 1(33.3%) | 1(16.7%) | 0.838 |
| Anterior segment wash + IOAB(Resurgery 1) | 3(33.3%) | 1(33.3%) | 1(33.3%) | 3(50%) | 0.916 |
| Corneo-scleral patch graft/TKP + IOL explant.(Resurgery 2) | 5(55.6%) | 2(66.7%) | 1(33.3%) | 4(66.7%) | 0.923 |
ANTIMICROBIAL SENSITIVITY
Disc diffusion by Kirby Bauer’s method showed us 100 % susceptibility of all the Nocardia isolates to amikacin. We found that vancomycin (86%) co-trimoxazole(86%), tobramycin(81%) and also linezolid(81%) were sensitive against most of the Nocardia isolates. 2 isolates of Nocardiafarcinica particularly showed resistance vancomycin. While ceftazidime resistance was shown by 2 isolates of N.farcinica, 2 isolates of N.asteroides, and 1 of N.cyriacigeorgica. Overall 10 (47%) isolates showed resistance to ceftazidime. 17 nocardia isolates showed Ampicillin resistance which was previously used in treatment of systemic and ocular Nocardia infections.
Only 4.7% isolates showed sensitivity to ampicillin. Similarly sensitivity to amoxcillin-clavulanic acid was seen in 14% isolates and 8 isolates showed resistance. While quinilones (moxifloxacin, ofloxacin, gatifloxacin) showed an average 70% susceptibility to nocardia with no resitance. They are still effectively used topically against nocardia infections.

Table 14: Antimicrobial sensitivity in % of isolates susceptibility and no. of resistant species
Discussion
The purpose of this study was to understand nocardiaendophthalmitis clinically and microbiologically and study its disease pattern.
Nocardia are gram positive filamentous bacteria belonging to class Actinobacteridea and are soil saprophytes. They stain positively with 1% acid fast ZN stain, Gram stain and grow on SDA and Blood agar.
It can present systemically with pneumonia, cutaneous nocardiosis, cerebral abscess or disseminate systemically.(36,48). In endophthalmtis previous studies have clearly shown that the clinico-microbiology of exogenous and endogenous endophthalmitis caused by Nocardia are different. Endogenous endophthalmitis usually occurs due to dissemination of Nocardia into the ocular structures from other organs like lungs , kidenys or brain(14,49–51). It has poor prognosis and has proven to be fatal.(25,52) Endogenous entity involves posterior segment more commonly than the anterior segment. It leads to scleral thickening, sub-retinal abscess or sometimes choroidal abscess.(14,25,53) Visual outcome is poor.
Exogenous endophthalmitis caused by Nocardia predominantly involves the anterior segment and is seen in cases of trauma or as a complication in postoperative cases as seen in our study.
In our study Nocardia was isolated from 21 out of 55 (38%) reported cases of endophthalmitis which was higher compared to the isolation rate (16.1%) of the study conducted by Haripriya A et al.(26)Lalitha P et al showed 31.5% isolation of Nocardia by culture from endophthalmitis cases.(16). All the cases were sporadic and there was no incidence of cluster infection.
Common age group of presentation of Nocardia infections was reported as 51 to 80 years in a study done by P.Manikandan et al.(54) Although they did include patients with endophthalmitis and keratitis. Age of the patient reported with chronic Nocardiaasteroidesendophtalmitis by Zimmerman et al was 65 years.(12) In a large retrospective study on Nocardiaendophthalmitis by A.Haripriya et al mean age of presentation was 67.3 years with a range from 49 to 85 years.(26). In our study we found similar results. Mean age of patients was 64.62 +/- 8.78 years in a range of 45 to 80 years. This is probably due to common age group of majority of patients undergoing cataract surgery.
Male gender was found to be more common in our study 12 out of 21 (57%)cases. In most of the published reports, male predominance was clearly delineated. According to Matulionyte et al, it may be related to the hormonal effects on the virulence or growth of Nocardia.(55)
Nocardiosis is more commonly seen in patients with underlying HIV(human immunodeficiency virus) infection, cancer, obstructive pulmonary disease.(36) There are reports of Nocardiaendophthalmitis in patients with SLE (Systemic Lupus Erythematosus), Behcets disease and lymphomas, which indicates role of autoimmunity and immunosuppression.(50,53,56). One of the limitation of our study is we did not study the blood parameters for immunocompromised status and systemic involvement.
In our series 12 out of 21 cases (57%) had a mature or a hard brown cataract which might require a larger surgical section. We did not have any incidence of posterior capsular rent but section was sutured in 2 cases, zonular dialysis was seen in 1 patient and small pupil was seen in 1 case. Our case series did not include ECCE with 5 sutures compared to study by Haripriya A et al.(26)
The median time interval from surgery to onset of symptoms was 25.6 days ranging from 13-64 days in the study by Haripriya A et al.(26) In our study the mean interval from surgery to onset of symptoms was 15.24 +/- 14.14 days ranging from 2 to 66 days. Time interval between surgery to symptoms was not associated with the final visual outcome, and this is probably because this interval coincides with the incubation period of the Nocardia, but the significant changes occur after the Nocardia manifests clinically.
The day of presentation of Nocardiaendophthalmitis of 2 patients in a case report by Gokhale et al was 17 days and 34 days respectively after phacoemulsification.(22) In a another series the day of presentation was 4-18 days after cataract surgery.(28) In the study by Decroos et al mean duration from surgery to presentation was 47.5 +/-49.4 days.(20) They found that presentation of patients within 10 days of symptoms was not associated with the final BCVA. Also According to the large case series by Haripriya A. et al , majority of their patients 17/24 had onset of symptoms in 3rd to 4th week and the patients presented to the hospital 4 to 13 days after surgery. This was significantly associated with the final visual outcome. (26)
In our study the mean day of presentation of patients was 26.81+/-18.44 ranging from 4 to 76 days and we found similar results of it being associated to the anatomical visual outcome with a suggestive significance (P= 0.084, Suggestive significance = 0.05<P<0.10) and the functional visual outcome with a suggestive significance (P= 0.088, Suggestive significance = 0.05<P<0.10). Also in our study the time taken by the patient to reach hospital after onset of symptoms was calculated separately as ‘delay by the patient to seek help’ and this was ranged from 1 to 54 days with a mean of 11.57 +/- 11.29 days. We found that this was also associated with functional visual outcome (P= 0.090 Suggestive significance = 0.05<P<0.10 ) with suggestive significance. Thus it emphasizes on importance of time and early presentation to the hospital in case of Nocardiaendophthalmitis.
Vision at presentation in the study by Haripriya A et al was <6/6000 (HM at 2 feet, +3 logMAR) in 16 out of 24 cases (69%).(26) In our study, vision at presentation was <or=6/6000 (+3 logMAR, HM at 2 feet) in 15 out of 21 (71.4%). The best presenting vision in the study by Haripriya A et al was 20/60 (6/18, +0.47 logMAR) and number of cases presenting with vision less than 6/600 (Counting fingers at 2 feet, +2 logMAR) were 8 (33%).(26) In our study the best presenting vision was 4/60 (+1.18 logMAR) and number of patients presenting with vision less than 6/600(counting fingers at 2 feet, +2 logMAR) were 2 out of 21 (9.5%). In both the studies presenting vision in almost 70 % cases was poor with hand motions at 2 feet. In the study by Haripriya A et al none of the patients presenting with vision light perception (PL+) could achieve better visual outcome. The three patients who obtained final visual acuity of 6/24 or better all presented with visual acuity of 5/60 or better.(26) Similarly in our study 2 out of 3 patients who achieved successful functional visual outcome presented with vision better than 6/600(counting fingers at 2 feet, +2 logMAR). We found significant association with initial presenting vision with the anatomical visual outcome visual outcome (p=0.008) and with functional visual outcome (p=0.004) which was similar to the findings in other studies.
The first 3 cases reported by Meyer et al and other case reports by Atkinson et al, Zimmerman et al highlighted anterior segment findings like yellowish nodules over cornea iris and pupil and whitish puff-ball opacities in anterior vitreous.(11,12,25) Even the recent case reports by Gokhale et al and ZS Pradhan et al mention predominant presenting finding of corneal infiltrates and anterior chamber exudates.(22,42) 12 out of 16 (75%) patients in the series studied by Decroos et al, had presented with distinctive anterior chamber findings, yellowish white anterior chamber exudates.(20) Anterior segment signs were pre-dominantly more than posterior segment with previous studies and case reports.
The study by Haripriya A. et al was the first one to document wound infections as presenting clinical feature. 11 out of 24 (45.83%) patients in their study had wound infections.(26) Their study had 7 ECCEs (Extracapsular cataract extractions) with intact sutures, 3 manual SICS and 1 phacoemulsification. In our study we reported of surgical sectional infiltrates in 16 out of 21 cases (76%) out of which 1 case had undergone phacoemulsification and 1 underwent lens removal along with capsular bag with sutures while remaining cases underwent manual SICS through a temporal tunnel. In the study by Haripriya A et al, characteristic cotton ball AC exudates were seen in 8 patients (33%), corneal fluffy exudates were seen in 7 patients (29%) , scleral abscess was seen in 3 cases and hypopyon was reported in 10 cases (41%). Compared to that in our study we came across AC exudates and surgical wound infections in majority of cases 16 (76%). Corneal exudates were present in 14 (66.6%), scleral abscess formation was seen in 7 cases (33%). Posterior segment involvement was comparatively lesser than anterior segment findings in both the studies. PPV was needed in only 3 cases in the study by Haripriya A et al.(26) In our study, we also included presence of mild vitritis in the posterior segment involvement which was seen in 13 cases(62%), but dense vitreous exudates needing PPV was seen in 3 cases (14%) and Retinal detachment was seen in 2 (9.5%)cases. Thus anterior segment findings of AC exudates, surgical sectional infiltrates and corneal endothelial exudates were more common than the posterior segment findings which was similar in observation with previous studies.
We also tried to find association of these clinical features with the anatomical and functional visual outcome, but there was no significant association between the two(P>0.1), which was similar to the study done by Haripriya A et al.(26)
Of all the clinical findings presence of scleral abscess (P=0.123 P>0.1 not significant) and membrane over IOL (P=0.123) showed the least of P values in association with anatomical visual outcome. Similarly presence of sectional infiltrates in association to functional visual outcome showed a P = 0.128. This suggests to look for these factors in a subsequent study with larger sample size. Though there is no significant association with visual outcome, the predominant anterior segment and wound involvement should aid in early diagnosis and starting appropriate therapy.
Most frequent sample of isolation yielding culture positivity was AC exudates in our study and it was similar with other studies.(20,26) Vitreous tap and vitreous biopsies yielded positive culture in few cases. Nocardia typically showed delayed culture positivity on 3rd to 4th day compared to other pathogenic bacteria which show culture positivity within 2 days.(57,58) Thus it is important to inform the microbiologist of the clinical suspicion and to specifically look for nocardia growth upto 5-6 days. We tried to find the source of Nocardia infection by culturing nail clippings on SDA and blood agar, but on all the occasions we encountered aggressive growth of fungi and commensals because of which we had to exclude the nail clippings from the study.
MALDI-TOF is a rapid, reliable and fairly accurate test to identify nocardia species giving 88% accuracy in results.(24) Although the gold standard to identify species is genetic method of DNA-DNA hybridization, 16sRNA analysis, due to economical constraints we opted for MALDI-TOF. This is the first report of MALDI-TOF analysis for nocardia species in post-operative endophthalmitis cases in India.
When it comes to the eye, common Nocardia species affecting the eye are N.arthritidis, N.neocaledoniensis, N.asiatica, N.asteroides, N.brasiliensis, N.pseudobrasiliensis, N.farcinica, N.cyriacigeorgica, N.otitidiscaviarum. Most of these organisms lead to Nocardia keratitis, scleritis.(18,21,44).
AK Reddy et al identified certain species of nocardia leading to endogenous infections like N.farcinica, N abscessus, N.brasiliensis, N.levis, N.otitidiscaviarum, N.amamiensis, N.puris, N.beijingensis, N.thailandaica and also according to a case report a latest species of nocardiaN.veterana has been found to cause endogenous endophthalmitis in a post cardiac-stent patient.(32,59–61)
Exogenous post-operative endophthalmitis involves more of anterior segment and particularly N.asteroides is one of the common nocardia species involved in its pathology as seen in many old and recent case reports.(12)(22) We have identified 6 isolates of N.farcinica(28.6%), 3 isolates of N.cyriacigeorgica(14.3%), and 3 of N.asteroides(14.3%) organisms of which the later one N.asteroides is known to cause post-operative infections. On The other hand Nocardiafarcinica has been isolated from a single case of exogenous endophthalmitis with a infection of Baerveld implant in a patient having Boston type 1 keratoprosthesis.(62). Nocardiacyriacigeorgica has not yet been reported in exogenous post-operative endophthalmitis. Thus N.cyriacigeorgica and N.farcinica which are comparatively rare organisms involved in post-operative endophthalmitis have been found most frequently in our study.
There was no significant association between individual species and any specific clinical features This suggests that probably the basic pathogenic mechanism of all nocardia species is the same and it presents similarly. Moresoever predominant anterior segment involvement is probably related to the site of inoculation of the organism than its individual species. Also there was no association between type of treatment modality or re-surgery with individual species.
All the species were sensitive to amikacin (100%). Amikacin has shown uniform sensitivity patterns through out all Nocardial isolates all over the world and we have found similar results in our study.(35,36)(18) A report by Pradhan ZS showed improvement of signs and symptoms by topical and oral co-trimoxazole along-with dexamethasone.(42) Our study also showed 86% susceptibility to co-trimoxazole. But though co-trimoxazole is one of the important drug used in treatment of Nocardia infections, study by Sridhar et al have shown reduced sensitivity to co-trimoxazole.(41). Systemic study reports have shown multi-drug resistant Nocardiafarcinica species resistant to co-trimoxazole, in which finally systemic linezolid and imipenem could bring about a clinical improvement.(29,45)Imipenem and linezolid are alternatives to co-trimoxazole for systemic therapy.(29) Linezolid has shown 100 % susceptibility in studies worldwide to nocardia.(36,63). All the strains of Nocardiafarcinica, cyriacigeorgica and asteroides have shown sensitivity to linezolid.(35) In our study too linezolid showed 81 % susceptibility to the isolates. Intra-vitreal linezolid has shown good results with lesser side effects in animal studies and thus linezolid can be used as a reserve drug in cases of resistant refractory infections.(64)
Compared to other studies which showed decreased susceptibility to vancomycin(12.5%), our study showed better susceptibility of vancomycin to Nocardia (86%).(26)Nocardiafarcinica has a high propensity for multiple drug resistance due to its genetic structure like IFM 1052 gene leading to beta lactam antibiotics resistance.(65,66) As seen in our study 2 isolates of Nocardiafarcinica showed resistance to the vancomycin and ceftazidime (beta lactam cephalosporins) and both of which needed corneo-scleral patch graft with IOL explantation. These are common antibiotics used in empirical treatment of endopthalmitis before diagnosis is proven by culture. To add to that a delayed culture positivity can delay the diagnosis and initiation of appropriate treatment. Thus its important to include amikacin in the initial empirical treatment as vancomycin and cefalosporins have reduced susceptibility to nocardia. But all the strains of Nocardiafarcinica showed sensitivity to linezolid and thus linezolid can be used as a reserve drug in cases of resistant refractory infections. An E-test is more accurate than disc diffusion method to get the exact MIC value, but due to economic constraints we could not conduct it in our study.(67)
In the initial study reports by Meyer et al the diagnosis was often confused with fungal endophthalmitis and patients were started on antifungal medications but due to no improvement in signs it led to enucleation.(25) While in some case reports the globe was salvaged by either topical and intra-vitreal antibiotics or multiple vitrectomies with intra-vitreal injections and IOL-capsular bag explantation. (11,22,28)
In the study by Decroos et al all 16 patients required surgical intervention.(20) 6 eyes needed PPV with repeat IOAB, out of which 4 needed anterior segment wash, 1 needed IOL explantation and 1 needed evisceration. 3 patients ended up with no perception of light. In our study 3 patients needed PPV, 2 of which needed anterior segment wash with IOAB, while 2 of the cases further needed therapeutic corneo-scleral patch grafts to save the globe. The visual outcome was hand motions and worse in two of these cases and counting fingers at 2 feet in one case.
On the other hand studies by Chen CJ and Gokhale et al reported of good visual outcome of 20/40 and 20/60 after therapeutic keratoplasties.(22,40) But in our study 12 out of 21 cases (57.1%) were refractory to the initial treatment had to eventually undergo a corneo-scleral patch graft or a therapeutic keratoplasty out of which only 1 had successful anatomical and functional outcome. Also keratoplasties in our study were used as a last resort to salvage the globe. Similarly in the study by Haripriya et al 4 patients underwent PPV and 1 needed therapeutic keratoplasty due to corneal perforation. Only 1 patient had good functional visual outcome.(26) We also correlated the treatment modalities with the anatomical and visual outcome but we found no significant association. This was probably because most of the patients presented after a delay and with poor vision.
Final visual outcome in our study was poor which showed only 3 (14%) patients obtaining vision better than 6/6000(+2 logMAR counting fingers at 2 feet) while 2 patients had 6/6000 vision. 16 patients (76%) had vision less than or equal to hand motions, with 6 patients having only perception of light and one with no perception of light. This was similar to study by Haripriya A et al which showed poor visual outcome with 79% patients having vision hand motions or less and 46 % patients with no perception of light.(26) The mean BCVA in the study by Decroos et al was 2.1+/-0.89 logMAR units (Snellen equivalent 6/755).(20)
Most common cause for anatomical failure in our study was presence of AC exudates followed by pthisisbulbiinspite of aggressive antimicrobial therapy at 3 months. This indicates towards need of long term antibiotic treatment and follow up.
The next step towards this problem is to identify the source of infection and try and prevent it. In Germany by Blümel J et al have isolated Nocardiafarcinica from the open air and changing rooms in operation theatre and also from the soil surrounding the wound.(39)Nocardia is a common inhabitant of soil in Southern India hence it is important to identify the source of infection by analyzing samples from nails, hair, or operation theatre and premises.(19)
Thus Nocardiaendophthalmitis is an aggressive disease has poor visual prognosis and prevention of infection can play a major role in visual prognosis.
CONCLUSION
Nocardia is a slow growing virulent species that leads to poor visual outcome in post-cataract endophthalmitis. Apart from Nocardiaasteroides, Nocardiafarcinica a multi-drug resistant organism and also Nocardiacyriacigeorgica can cause post-cataract endophthalmitis. It presents predominantly with surgical sectional infiltrates and exudates involving cornea and anterior chamber. There is no significant association between the patients age and gender, with the final visual outcome. Also there is no significant association between clinical features, individual species of Nocardia and different surgical interventions with the final visual outcome. Individual species of Nocardia had no association with specific clinical features and treatment modalities. Amikacin is the most sensitive antibiotic to Nocardia and should be given topically and intra-vitreally with other drugs as an empirical treatment. Newer drugs like linezolid are a good alternative treatment options. Better visual prognosis depends on the early presentation to the hospital and better vision at presentation. Early diagnosis with the help of rapid diagnostic methods and characteristic clinical features can help in initiating appropriate therapy to save the vision.
Bibliography
- Murthy G, Gupta S, John N, Vashist P. Current status of cataract blindness and Vision 2020: The right to sight initiative in India. Indian J Ophthalmol. 2008 Jan;56(6):489.
- Dandona L, Dandona R, Anand R, Srinivas M, Rajashekar V. Outcome and number of cataract surgeries in India: policy issues for blindness control. Clin Experiment Ophthalmol. 2003 Feb;31(1):23–31.
- Safneck JR. Endophthalmitis: A review of recent trends. Saudi J Ophthalmol Off J Saudi Ophthalmol Soc. 2012 Apr;26(2):181–9.
- Ng JQ, Morlet N, Pearman JW, Constable IJ, McAllister IL, Kennedy CJ, et al. Management and outcomes of postoperative endophthalmitis since the endophthalmitis vitrectomy study: the Endophthalmitis Population Study of Western Australia (EPSWA)’s fifth report. Ophthalmology. 2005 Jul;112(7):1199–206.
- Ramakrishnan R, Bharathi MJ, Shivkumar C, Mittal S, Meenakshi R, Khadeer MA, et al. Microbiological profile of culture-proven cases of exogenous and endogenous endophthalmitis: a 10-year retrospective study. Eye (Lond). 2009 Apr;23(4):945–56.
- Wong TY, Chee S-P. The epidemiology of acute endophthalmitis after cataract surgery in an Asian population. Ophthalmology. 2004 Apr;111(4):699–705.
- Gentile RC, Shukla S, Shah M, Ritterband DC, Engelbert M, Davis A, et al. Microbiological spectrum and antibiotic sensitivity in endophthalmitis: a 25-year review. Ophthalmology. 2014 Aug;121(8):1634–42.
- Han DP, Wisniewski SR, Wilson LA, Barza M, Vine AK, Doft BH, et al. Spectrum and susceptibilities of microbiologic isolates in the Endophthalmitis Vitrectomy Study. Am J Ophthalmol. 1996 Jul;122(1):1–17.
- Anand AR, Therese KL, Madhavan HN. Spectrum of aetiological agents of postoperative endophthalmitis and antibiotic susceptibility of bacterial isolates. Indian J Ophthalmol. 2000 Jun;48(2):123–8.
- Narang S, Gupta A, Gupta V, Dogra MR, Ram J, Pandav SS, et al. Fungal endophthalmitis following cataract surgery: clinical presentation, microbiological spectrum, and outcome. Am J Ophthalmol. 2001 Nov;132(5):609–17.
- Atkinson PL, Jackson H, Philpott-Howard J, Patel BC, Aclimandos W. Exogenous Nocardia asteroides endophthalmitis following cataract surgery. J Infect. 1993 May;26(3):305–8.
- Zimmerman PL, Mamalis N, Alder JB, Teske MP, Tamura M, Jones GR. Chronic Nocardia asteroides endophthalmitis after extracapsular cataract extraction. Arch Ophthalmol (Chicago, Ill 1960). 1993 Jun;111(6):837–40.
- Hung J-H, Huang Y-H, Chang T-C, Tseng S-H, Shih M-H, Wu J-J, et al. A cluster of endophthalmitis caused by Mycobacterium abscessus after cataract surgery. J Microbiol Immunol Infect. 2014 Mar 20;
- Yu E, Laughlin S, Kassel EE, Messner HA, Yucel YH. Nocardial Endophthalmitis and Subretinal Abscess: CT and MR Imaging Features with Pathologic Correlation: A Case Report. AJNR Am J Neuroradiol. 2005 May 1;26(5):1220–2.
- Compte RB, Martínez-Osorio H, Carrasco G, Lorente B, Elizalde J, Valdezate S, et al. Traumatic endophthalmitis caused by Nocardia kruczakiae in a patient with traumatic eye injury. J Ophthalmic Inflamm Infect. Springer; 2015 Dec 25;5(1):36.
- Lalitha P, Rajagopalan J, Prakash K, Ramasamy K, Prajna NV, Srinivasan M. Postcataract endophthalmitis in South India incidence and outcome. Ophthalmology. 2005;112(11):1884–9.
- Sridhar MS, Sharma S, Reddy MK, Mruthyunjay P, Rao GN. Clinicomicrobiological review of Nocardia keratitis. Cornea. 1998 Jan;17(1):17–22.
- Lalitha P, Tiwari M, Prajna NV, Gilpin C, Prakash K, Srinivasan M. Nocardia keratitis: species, drug sensitivities, and clinical correlation. Cornea. 2007 Apr;26(3):255–9.
- Mishra SK, Damodaran VN. Observations on the natural habitats of Cryptococcus neoformans and Nocardia asteroides. Indian J Chest Dis. 1973 Oct;15(4):263–71.
- DeCroos FC, Garg P, Reddy AK, Sharma A, Krishnaiah S, Mungale M, et al. Optimizing diagnosis and management of nocardia keratitis, scleritis, and endophthalmitis: 11-year microbial and clinical overview. Ophthalmology. 2011 Jun;118(6):1193–200.
- Yin X, Liang S, Sun X, Luo S, Wang Z, Li R. Ocular nocardiosis: HSP65 gene sequencing for species identification of Nocardia spp. Am J Ophthalmol. 2007 Oct;144(4):570–3.
- Gokhale N, Garg P, Rodrigues C, Haldipurkar S. Nocardia infection following phacoemulsification. Indian J Ophthalmol. 2007 Jan;55(1):59.
- Panda A, Kurapati S, Samantaray JC, Srinivasan A, Khalil S. MALDI-TOF mass spectrometry proteomic based identification of clinical bacterial isolates. Indian J Med Res. 2014 Dec;140(6):770–7.
- Verroken A, Janssens M, Berhin C, Bogaerts P, Huang T-D, Wauters G, et al. Evaluation of matrix-assisted laser desorption ionization-time of flight mass spectrometry for identification of nocardia species. J Clin Microbiol. 2010 Nov;48(11):4015–21.
- Meyer SL. Intraocular Nocardiosis. Arch Ophthalmol. 1970 May;83(5):536.
- Haripriya A, Lalitha P, Mathen M, Prajna NV, Kim R, Shukla D, et al. Nocardia endophthalmitis after cataract surgery: clinicomicrobiological study. Am J Ophthalmol. 2005;139(5):837–46.
- Cacchillo PF, Ciulla TA, Strayer T, Fisher M, Massicotte S. Nocardia endophthalmitis following uncomplicated phacoemulsification and implantation of a posterior chamber intraocular lens. Ophthalmic Surg Lasers. 2000 Jan 2;31(1):64–5.
- Srinivasan M. Nocardial Endophthalmitis. Arch Ophthalmol. 1994 Jul;112(7):871.
- Hitti W, Wolff M. Two cases of multidrug-resistant Nocardia farcinica infection in immunosuppressed patients and implications for empiric therapy. Eur J Clin Microbiol Infect Dis. 2005 Feb;24(2):142–4.
- Alfaro D V, Hudson SJ, Kasowski EJ, Barton CP, Brucker AJ, Lopez JD, et al. Experimental pseudomonal posttraumatic endophthalmitis in a swine model. Treatment with ceftazidime, amikacin, and imipenem. Retina. 1997 Jan;17(2):139–45.
- Miriam AS, D’Aversa G, Sable M, Farbowitz M, Sorenson J, Green WR. Retinal Toxicity of Intravitreal Sparfloxacin, Ofloxacin, and Imipenem in a Rabbit Model. J Toxicol Cutan Ocul Toxicol. 2008 Sep;18(1):65–73.
- Scott M, Mehta S, Rahman HT, Grossniklaus HE, Yeh S. Nocardia veterana endogenous endophthalmitis in a cardiac transplant patient. J Ophthalmic Inflamm Infect. 2013 Jan;3(1):44.
- Lewis KE, Ebden P, Wooster SL, Rees J, Harrison GAJ. Multi-system Infection with Nocardia farcinica—Therapy with Linezolid and Minocycline. J Infect. 2003 Apr;46(3):199–202.
- Larruskain J, Idigoras P, Marimón JM, Pérez-Trallero E. Susceptibility of 186 Nocardia sp. isolates to 20 antimicrobial agents. Antimicrob Agents Chemother. 2011 Jun;55(6):2995–8.
- McTaggart LR, Doucet J, Witkowska M, Richardson SE. Antimicrobial susceptibility among clinical Nocardia species identified by multilocus sequence analysis. Antimicrob Agents Chemother. 2015 Jan;59(1):269–75.
- Minero MV, Marín M, Cercenado E, Rabadán PM, Bouza E, Muñoz P. Nocardiosis at the turn of the century. Medicine (Baltimore). 2009 Jul;88(4):250–61.
- Joshi N, Hamory BH. Drug-resistant Nocardia asteroides infection in a patient with acquired immunodeficiency syndrome. South Med J. 1991 Sep;84(9):1155–6.
- Pandya VB, Petsoglou C. Nocardia transvalensis resistant to amikacin: an unusual cause of microbial keratitis. Cornea. 2008 Oct;27(9):1082–5.
- Blümel J, Blümel E, Yassin AF, Schmidt-Rotte H, Schaal KP. Typing of Nocardia farcinica by pulsed-field gel electrophoresis reveals an endemic strain as source of hospital infections. J Clin Microbiol. 1998 Jan;36(1):118–22.
- Chen CJ. Nocardia asteroides endophthalmitis. Ophthalmic Surg. 1983 Jun;14(6):502–5.
- Sridhar MS, Gopinathan U, Garg P, Sharma S, Rao GN. Ocular nocardia infections with special emphasis on the cornea. Surv Ophthalmol. Jan;45(5):361–78.
- Pradhan Z, Korah S, Jacob P. Management of post-operative Nocardia endophthalmitis. Indian J Med Microbiol. 2012 Jul;30(3):359.
- Results of the Endophthalmitis Vitrectomy Study. Arch Ophthalmol. 1995 Dec;113(12):1479.
- Lalitha P. Nocardia keratitis. Curr Opin Ophthalmol. 2009 Jul;20(4):318–23.
- Shen T, Wu L, Geng L, Wei Z, Zheng S. Successful treatment of pulmonary Nocardia farcinica infection with linezolid: case report and literature review. Braz J Infect Dis. Jan;15(5):486–9.
- Wallace RJ, Steele LC. Susceptibility testing of nocardia species for the clinical laboratory. Diagn Microbiol Infect Dis. 1988 Mar;9(3):155–66.
- Holladay JT. Proper method for calculating average visual acuity. J Refract Surg. 1996 Jan;13(4):388–91.
- Torres OH, Domingo P, Pericas R, Boiron P, Montiel JA, Vázquez G. Infection Caused by Nocardia farcinica : Case Report and Review. Eur J Clin Microbiol Infect Dis. 2000 Apr;19(3):205–12.
- Bozbeyoglu S, Yilmaz G, Akova YA, Arslan H, Aydin P, Haberal M. Choroidal abscess due to nocardial infection in a renal allograft recipient. Retina. 2004 Feb;24(1):164–6.
- Rogers SJ, Johnson BL. Endogenous Nocardia endophthalmitis: report of a case in a patient treated for lymphocytic lymphoma. Ann Ophthalmol. 1977 Sep;9(9):1123–31.
- Panijayanond P. Intraocular Nocardiosis in a Renal Transplant Patient. Arch Surg. 1972 Jun;104(6):845.
- Budzik JM, Hosseini M, Mackinnon AC, Taxy JB. Disseminated Nocardia farcinica: literature review and fatal outcome in an immunocompetent patient. Surg Infect (Larchmt). 2012 Jun;13(3):163–70.
- Yap EY, Fam HB, Leong KP, Buettner H. Nocardia choroidal abscess in a patient with systemic lupus erythematosus. Aust N Z J Ophthalmol. 1998 Nov;26(4):337–8.
- Manikandan P, Bhaskar M, Revathi R, Anita R, Abarna Lakshmi LR, Narendran V. Isolation and antimicrobial susceptibility pattern of Nocardia among people with culture-proven ocular infections attending a tertiary care eye hospital in Tamilnadu, South India. Eye (Lond). 2007 Aug;21(8):1102–8.
- Matulionyte R, Rohner P, Uçkay I, Lew D, Garbino J. Secular trends of nocardia infection over 15 years in a tertiary care hospital. J Clin Pathol. 2004 Aug;57(8):807–12.
- Korkmaz C, Aydinli A, Erol N, Yildirim N, Akgtün Y, Inci R, et al. Widespread nocardiosis in two patients with Behçet’s disease. Clin Exp Rheumatol. Jan;19(4):459–62.
- Wells EJ, Franco LM, Price CTD, Graham JE, Barr CC. Effect of blood on susceptibility to Staphylococcal endophthalmitis. Retina. 2007 Oct;27(8):1125–30.
- Durand ML. Endophthalmitis. Clin Microbiol Infect. 2013 Mar;19(3):227–34.
- Reddy AK, Garg P, Kaur I. Speciation and susceptibility of Nocardia isolated from ocular infections. Clin Microbiol Infect. 2010 Aug;16(8):1168–71.
- Chen LY, Kesen MR, Ghafourian A, Nguyen QD, Eberhart CG, Do D V. Isolated endogenous Nocardia endophthalmitis after immunosuppression. J Ophthalmic Inflamm Infect. 2012;2(3):141–3.
- Kawakami H, Sawada A, Mochizuki K, Takahashi K, Muto T, Ohkusu K. Endogenous Nocardia farcinica endophthalmitis. Jpn J Ophthalmol. 2010 Mar;54(2):164–6.
- Tsui I, Uslan DZ, Hubschman J-P, Deng SX. Nocardia farcinica Infection of a Baerveldt implant and endophthalmitis in a patient with a Boston type I keratoprosthesis. J Glaucoma. Jan;19(5):339–40.
- Hashemi-Shahraki A, Heidarieh P, Bostanabad SZ, Hashemzadeh M, Feizabadi MM, Schraufnagel D, et al. Genetic diversity and antimicrobial susceptibility of Nocardia species among patients with nocardiosis. Sci Rep. 2015 Jan;5:17862.
- Saleh M, Lefèvre S, Acar N, Bourcier T, Marcellin L, Prévost G, et al. Efficacy of intravitreal administrations of linezolid in an experimental model of S. aureus-related endophthalmitis. Invest Ophthalmol Vis Sci. 2012 Jul;53(8):4832–41.
- Wallace, R J J, Tsukamura M, Brown BA, Brown J, Steingrube VA, Zhang YS, et al. Cefotaxime-resistant Nocardia asteroides strains are isolates of the controversial species Nocardia farcinica. J Clin Microbiol. 1990 Dec;28(12):2726–32.
- Ishikawa J, Yamashita A, Mikami Y, Hoshino Y, Kurita H, Hotta K, et al. The complete genomic sequence of Nocardia farcinica IFM 10152. Proc Natl Acad Sci U S A. 2004 Oct;101(41):14925–30.
- Manoharan A, Pai R, Shankar V, Thomas K, Lalitha MK. Comparison of disc diffusion & E test methods with agar dilution for antimicrobial susceptibility testing of Haemophilus influenzae. Indian J Med Res. 2003 Feb;117:81–7.

